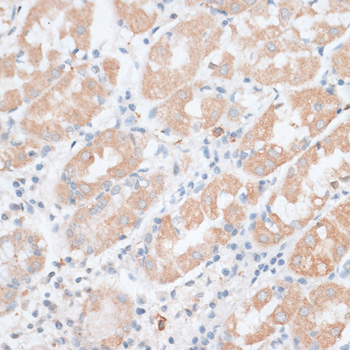

-
Product Name
PAEP Polyclonal Antibody
- Documents
-
Description
Polyclonal antibody to PAEP
-
Tested applications
IHC
-
Species reactivity
Human, Mouse, Rat
-
Alternative names
PAEP antibody; GD antibody; GdA antibody; GdF antibody; GdS antibody; PAEG antibody; PEP antibody; PP14 antibody; glycodelin antibody
-
Isotype
Rabbit IgG
-
Preparation
Antigen: Recombinant fusion protein containing a sequence corresponding to amino acids 19-180 of human PAEP (NP_002562.2).
-
Clonality
Polyclonal
-
Formulation
PBS with 0.02% sodium azide, 50% glycerol, pH7.3.
-
Storage instructions
Store at -20℃. Avoid freeze / thaw cycles.
-
Applications
IHC 1:50 - 1:200
-
Validations
Immunohistochemistry - PAEP Polyclonal Antibody
Immunohistochemistry of paraffin-embedded human stomach using PAEP antibody at dilution of 1:100 (40x lens).

Immunohistochemistry - PAEP Polyclonal Antibody
Immunohistochemistry of paraffin-embedded mouse pancreas using PAEP antibody at dilution of 1:100 (40x lens).
-
Background
Glycoprotein that regulates critical steps during fertilization and also has immunomonomodulatory effects. Four glycoforms, namely glycodelin-S, -A, -F and -C have been identified in reproductive tissues that differ in glycosylation and biological activity. Glycodelin-A has contraceptive and immunosuppressive activities. Glycodelin-C stimulates binding of spermatozoa to the zona pellucida. Glycodelin-F inhibits spermatozoa-zona pellucida binding and significantly suppresses progesterone-induced acrosome reaction of spermatozoa. Glycodelin-S in seminal plasma maintains the uncapacitated state of human spermatozoa.
Related Products / Services
Please note: All products are "FOR RESEARCH USE ONLY AND ARE NOT INTENDED FOR DIAGNOSTIC OR THERAPEUTIC USE"
